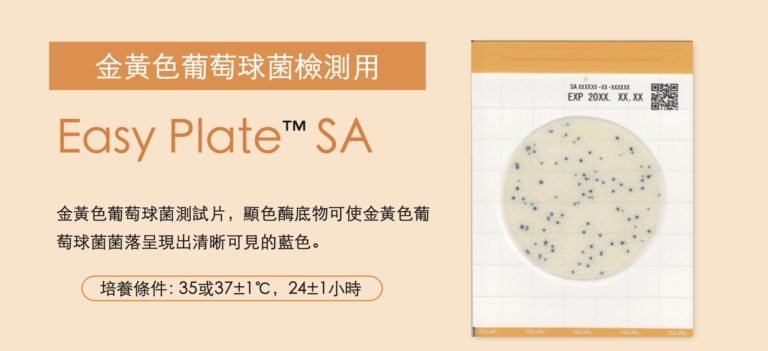
Easy Plate™ SA 金黃色葡萄球菌檢測片-太鼎食安科技

食品GHP、GMP、HACCP及EMP,你分得清楚嗎?
2024 年 4 月 15 日
包括良好衛生慣例(GHP)、良好製造規程(GMP)、危害分析和關鍵控制點(HACCP)以及環境監控計劃(EMP)。這些標準和計劃不僅是我們對品質的承諾,更是保證您的業務在競爭中脫穎而出的關鍵。

【M.R.S乳酸菌培養基】食品乳酸菌檢驗 MRS agar Test of Lactic Acid Bacteria貨號NCM0035A
2022 年 10 月 1 日
MRS瓊脂(MRS agar, MRSA)是培養和計數乳桿菌屬的培養基。食品總乳酸菌檢驗

Smart 手持式 ATP 微生物冷光儀-kikkoman 太鼎食安科技
2022 年 9 月 30 日
具有專利保護的ATP/ADP/AMP (A3) 循環檢測技術,增加了檢測的敏感度與穩定性。


